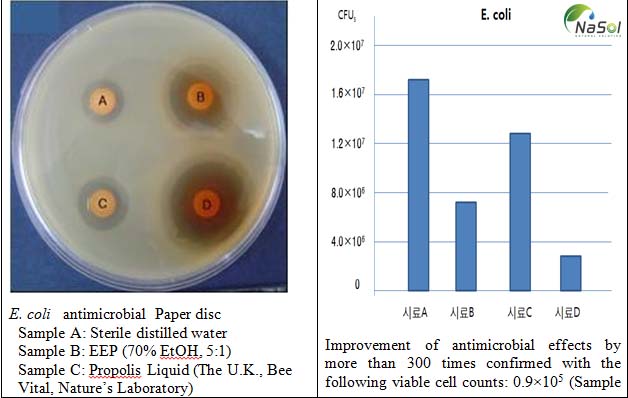
tác dụng của keo ong
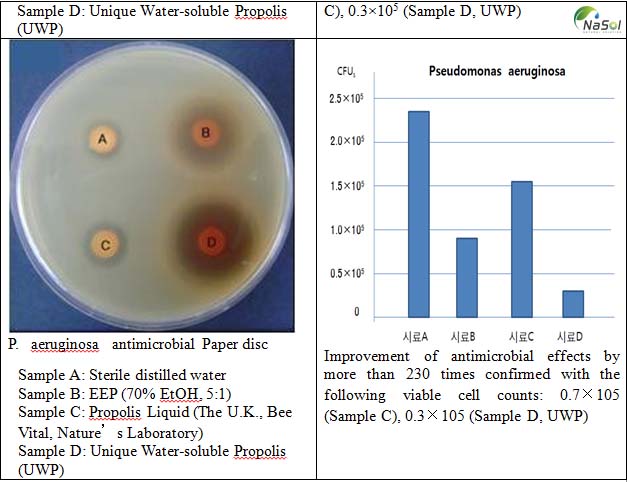
nguyên liệu keo ong

Tác dụng của keo ong với sức khỏe con người
Keo ong được biết đến nhiều như một nguyên liệu kháng sinh tự nhiên lành tính nhưng còn rất nhiều các tác dụng hữu ích khác của nguyên liệu thiên nhiên này đã được các nhà khoa học khám phá và công bố.
Kháng sinh tự nhiên
Trong y học cổ truyền, keo ong được dùng với tên thuốc là “phong giao”, có vị nhạt, tính bình, có tác dụng sát khuẩn mạnh. Y học hiện đại coi keo ong là “Liều thuốc kháng sinh tự nhiên hoàn hảo nhất” bởi qua nhiều nghiên cứu, đã cho thấy keo ong có khả năng tiêu diệt vi khuẩn gram dương (Staphylococci) và các vi khuẩn Gram âm (E.coli, K. pneumoniae, P. vulgaris và P. aeruginosa). Các nhà khoa học cũng tìm ra rằng trong keo ong có những hoạt chất kháng sinh tổng hợp chất streptomycin, cloxacillin, chloramphenicol, cefradine và polymyxis B. Bởi vậy keo có tác dụng tương đương sự phối hợp 4 loại kháng sinh là Penicilline, Streptomycine, Neomycine và Tetracyclline.
Xem thêm: Nguyên liệu Keo ong tan trong nước
Chống viêm
Keo ong với các thành phần chính bao gồm hỗn hợp như (Quercetin, artepillin-c, cinnamic acid, coumaric acid, caffeic acid..) có tác dụng kích thích sản xuất cytokine chống viêm, đặc biệt là chống viêm trực tiếp tại các vị trí bị tổn thương, kích thích tạo tế bào mới. Vì vậy, sản phẩm này có khả năng phòng chống viêm họng, viêm lợi, viêm xoang, viêm mũi, viêm mũi dị ứng, ho, cảm lạnh, cảm cúm, viêm hô hấp trên…
Cải thiện chức năng tiêu hóa
Theo nghiên cứu của Grange và Davey (1990): Ở liều lượng 3mg/ml, keo ong có hoạt tính tích cực đối với cầu khuẩn và vi khuẩn Gram+ và ức chế sự tăng trưởng của Staphylococcus aureus, Staph. epidermidis, Enterococcus spp., Corynebacterium spp., Branhamella catarrhalis và Bacillus cereus. Nó cũng tham gia ức chế một phần sự tăng trưởng của Pseudomonas aeruginosa và E.coli. Họ còn cho rằng, galangin và caffeic acid phenetyl ester trong chiết xuất keo ong là những nguồn chính của hiệu ứng nói trên.

(Nghiên cứu Unique Biotech. Co., ltd về khả năng ức chế sự phát triển vi khuẩn E.Coli và P. aeruginosa antimicrobial)
Ngoài ra, keo ong giúp giảm thiểu nguy cơ viêm loét dạ dày tá tràng do ức chế vi khuẩn Helicobacter pylori, nó có chất bảo vệ, thúc đẩy và phục hồi tái sinh các tổ chức bị tổn thương, khôi phục lại khả năng tồn tại của tế bào gốc, giúp nhanh chóng phục hồi các mô và chữa các bệnh về viêm loét. Đặc biệt, keo ong chứa nhiều enzyme có tác dụng cải thiện chức năng tiêu hóa.
Xét về tính chất quan trọng của keo ong, nó không tạo ra vi khuẩn kháng thuốc, đặc biệt, nó không ảnh hưởng đến hệ vi khuẩn đường ruột Lactobacillus bifidus và Lactobacillus.
Ngăn ngừa sâu răng
Các nghiên cứu thực hiện trong môi trường ống nghiệm trên 15 chủng vi khuẩn lâm sàng thường gặp trong nha khoa cho thấy chiết xuất keo ong có khả năng chống vi khuẩn, làm ức chế sự tăng sinh tế bào của vi khuẩn từ đó giúp ngăn ngừa sâu răng hiệu quả.
Chăm sóc và bảo vệ da
Keo ong cũng được biết đến là một sản phẩm giúp làm đẹp, có thể trong uống ngoài bôi. Uống keo ong không chỉ giúp loại bỏ các độc tố, thanh lọc máu, cải thiện vi tuần hoàn, mà còn loại bỏ mụn trứng cá, mụn đầu đen, các vết nám, đốm tàn nhang, giúp phái đẹp luôn có làn da trắng trẻo hồng hào.
Đặc biệt, Keo ong lành mạnh hơn so với bất kỳ loại kháng sinh khác trong việc kiểm soát Staphylococcus epidermidis (nguyên nhân chính gây mụn chứng cá), Vi nấm Pityrosporum (nguyên nhân gây ra gàu), và Trichomonas vaginalis (nguyên nhân gây ra viêm âm đạo).
Chống lão hóa
Các flavonoids trong keo ong có tác dụng bắt giữ các gốc tự do. Keo ong còn giúp kéo dài đời sống của tế bào lành, làm giảm các chứng và bệnh liên quan đến gốc tự do, vì vậy có tác dụng chống lão hóa và các bệnh do lão hóa gây ra.
Tốt cho huyết áp
Keo ong giàu chất flavonoids và chất chống oxy hóa, do đó, người bị tăng huyết áp sử dụng keo ong không chỉ có tác dụng ngăn ngừa xơ cứng động mạch, tai biến mạch máu não mà còn điều hòa cân bằng, giảm chất béo trung tính, giảm tập kết tiểu cầu, cải thiện vi tuần hoàn, giúp hạ, ổn định huyết áp, từ đó tránh được những biến chứng do tai biến gây ra.
Bảo vệ tế bào thần kinh, an thần
Cùng với tác dụng tăng tuần hoàn mạch máu, tác dụng chống oxy hóa, keo ong có tác dụng bảo vệ tế bào não và giảm nguy cơ mắc phải các bệnh Alzheimer, Parkinson, thoái hóa tế bào não…
Chống bức xạ, phóng xạ, chiếu xạ
Flavonoids trong keo ong có tác dụng hạn chế các tổn thương tế bào do bức xạ, phóng xạ, chiếu xạ do ức chế phản ứng oxy hóa. Bên cạnh đó, nó cũng thúc đẩy sự sinh trưởng của các mô tế bào, tăng cường phục hồi các tế bào bị tổn thương.
Ngăn ngừa ung thư
Keo ong có chứa flavonoids, hợp chất phenol, tecpen, polysaccharides, acid hữu cơ và các chất tự nhiên khác giúp ức chế đáng kể các tế bào ung thư. Các bệnh nhân ung thư sử dụng keo ong thường xuyên không chỉ ngăn chặn được sự di căn của tế bào ung thư, giảm tác dụng phụ do quá trình hóa trị và xạ trị gây nên mà còn từng bước nâng cao thể lực, tăng lượng bạch cầu trong máu.
Công ty TNHH Dược phẩm Quốc Tế Nasol giới thiệu dòng sản phẩm Solubpolis (Keo ong) tự nhiên phát triển công nghệ sản xuất sáp ong không cồn và có tính tan trong nước. Công nghệ này đã hoàn thành đăng kí sáng chế tại Hàn Quốc và nộp đơn đăng kí bản quyền quốc tế PCT. Vào năm 2016, công ty nhận được giải thưởng “Công nghệ mới lĩnh vực sản phẩm nông lâm”của chính phủ Hàn Quốc.
Chiết xuất Keo ong dạng nguyên liệu không chứa cồn hay các chất làm nhũ, chất phụ gia bảo quản, không hề có mùi vị của sáp hay nhựa và là sản phẩm tan hoàn toàn trong nước, không hề có bất cứ chất bảo quản gây hại cho cơ thể con người. Thích hợp dùng sản phẩm trong nhiều lĩnh vực như nguyên liệu sản xuất thực phẩm bảo vệ sức khỏe, thực phẩm bổ sung, mỹ phẩm.
Thông tin chi tiết vui lòng liên hệ:
Công ty TNHH Dược Phẩm Nasol Quốc Tế
Hotline: 0387 368 760
Email: info@nasol.com.vn Web: nasol.com.vn
Tin tức khác
- Axit Boswellic là gì? ứng dụng trong điều trị bệnh mãn tính
- Ngải cứu trắng (Artemisia herba-alba) là gì?
- Hồ đằng bốn cạnh (Cissus quadrangularis) là gì?
- Cỏ xạ hương (Thyme): thành phần hóa học và đặc tính trị liệu
- Phong lữ châu Phi: Thảo dược điều trị nhiễm trùng đường hô hấp
- Rosavin là gì? Nguồn gốc và các lợi ích sức khỏe
- Rễ Kava chữa rối loạn lo âu như thế nào?
- Curuminoid là gì? Cấu trúc nguồn gốc và ứng dụng thực tế
- Lợi ích sức khỏe của nghệ đen (Curcuma phaeocaulis)
- Lá Boldo (Peumus boldus): thành phần và công dụng
Tin nổi bật
Những lưu ý khi sử dụng Dầu nhuyễn thể
20/09/2021
Lợi ích sức khỏe của Tía tô đất (Lemon Balm)
17/09/2021